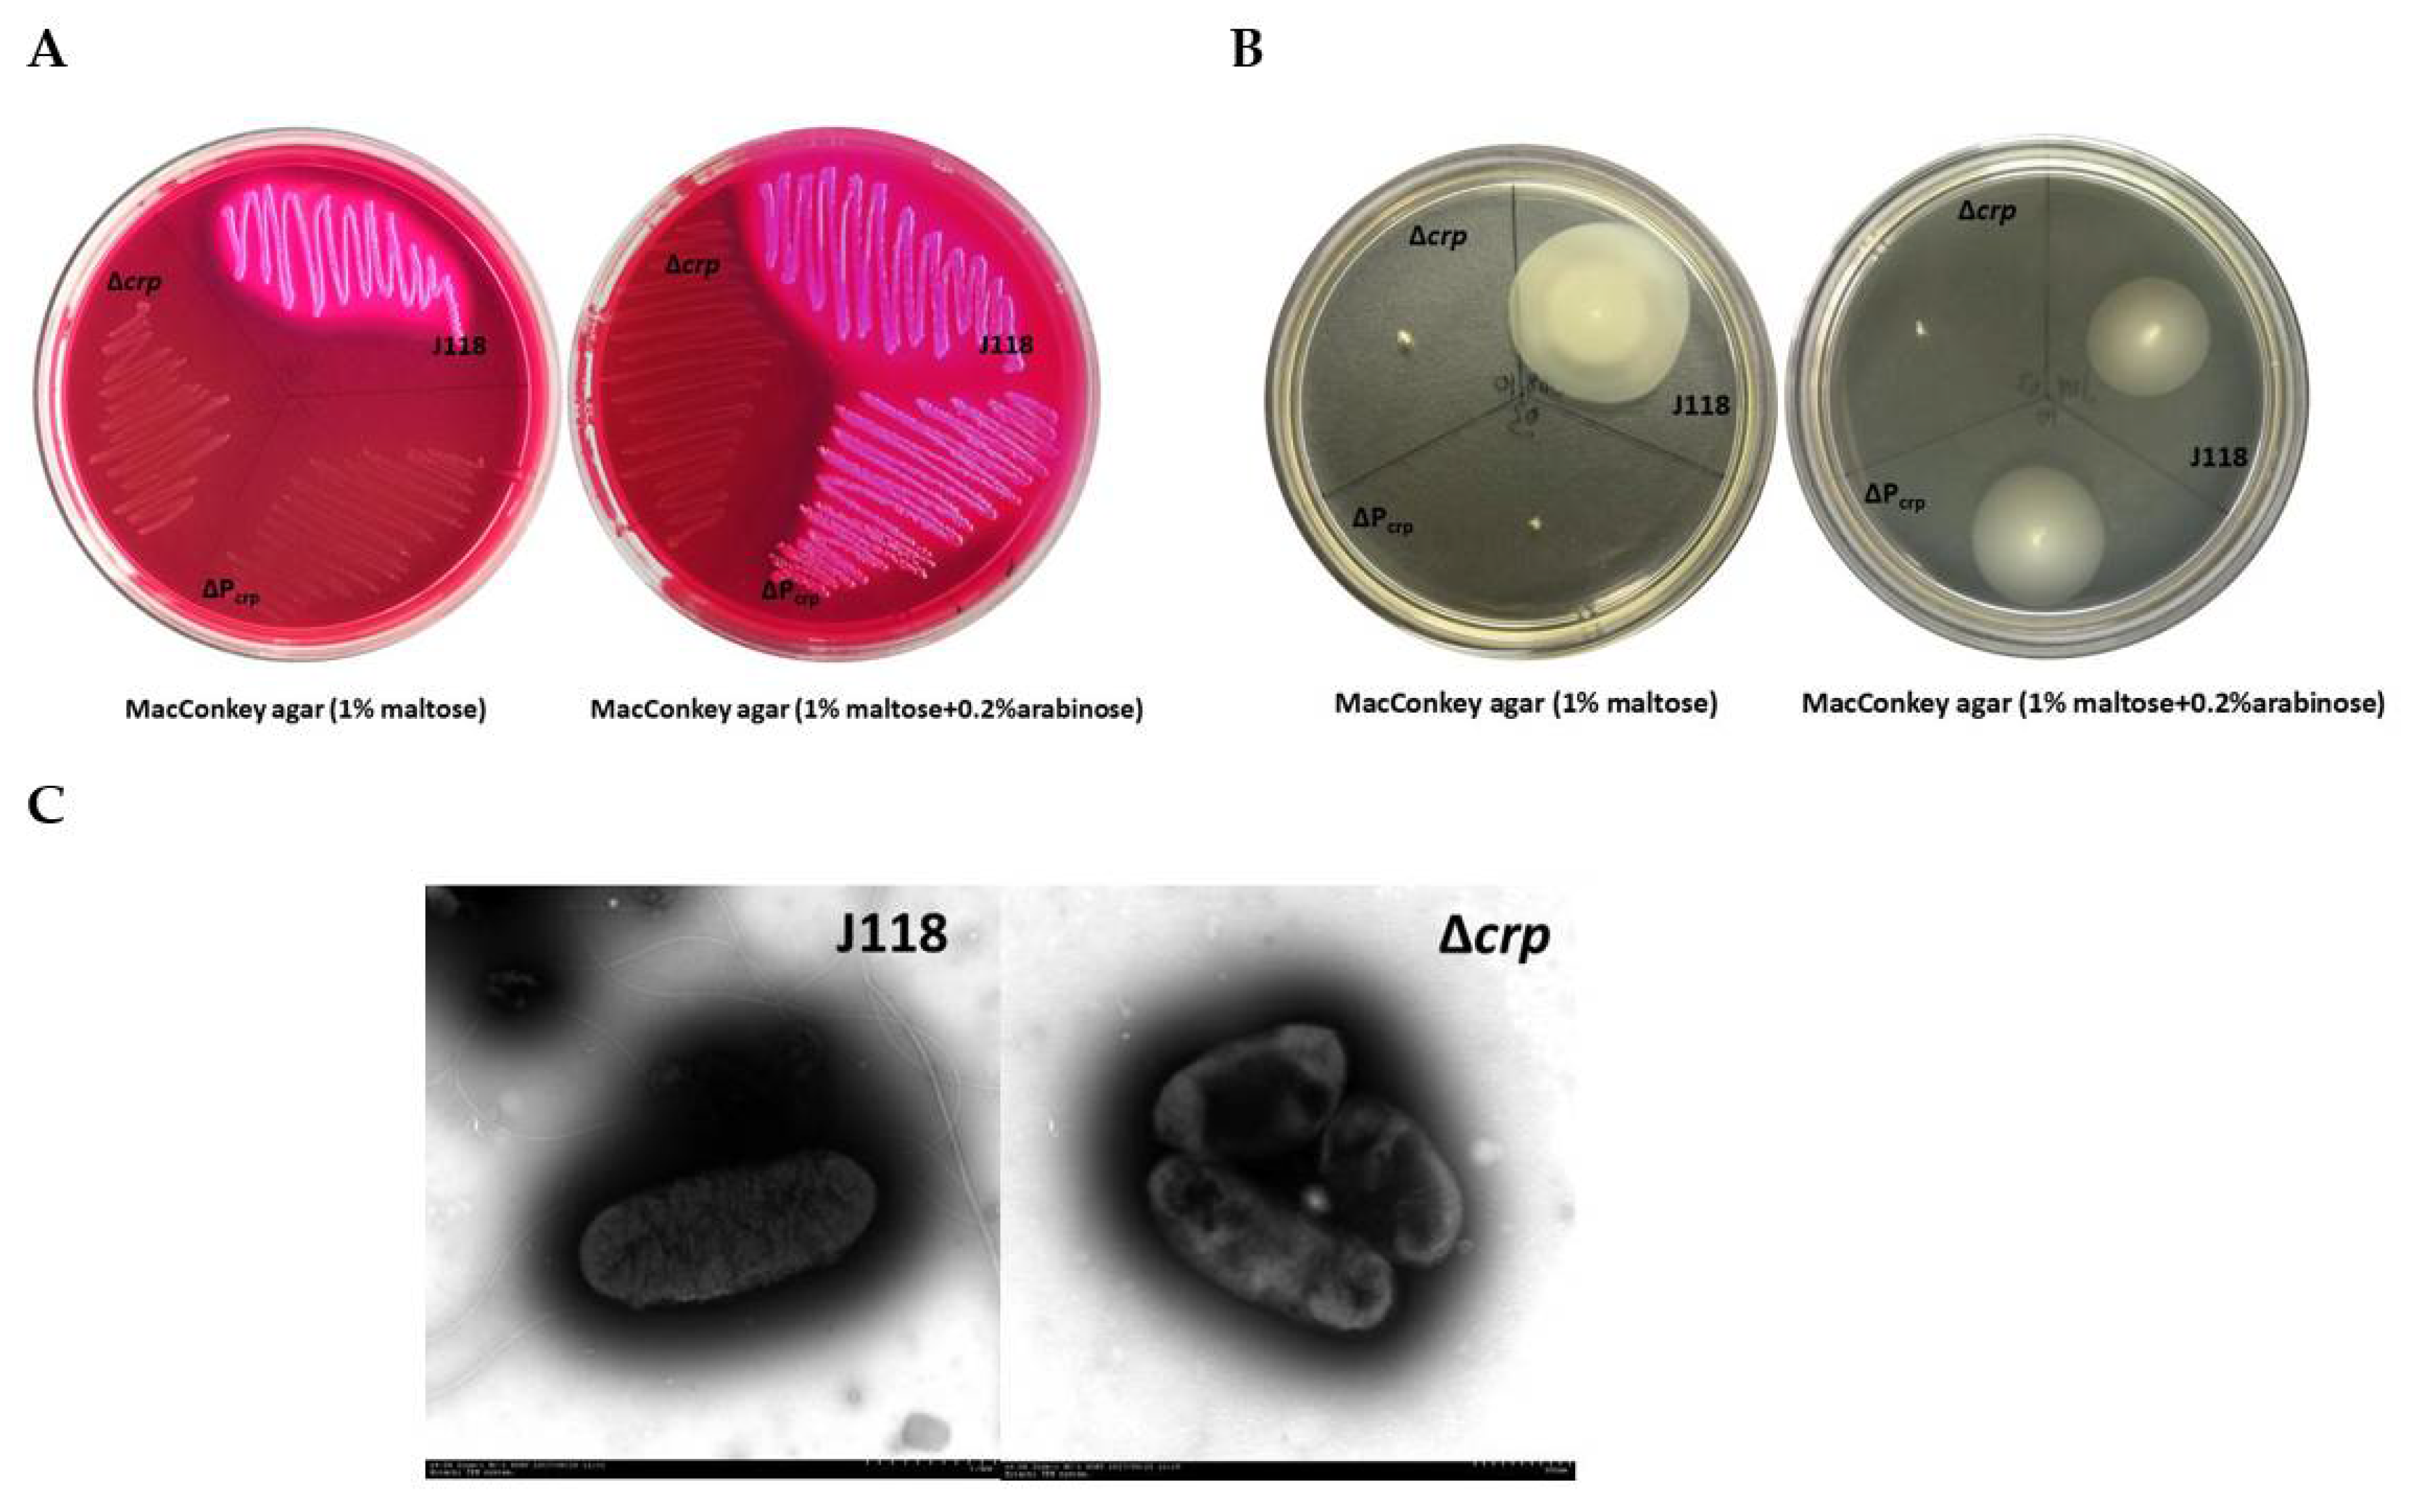
Microorganisms 08 00517 g004 Microorganisms 08 00517 g004

Phenotype, Virulence and Immunogenicity of Edwardsiella piscicida Cyclic AMP Receptor Protein (Crp) Mutants in Catfish Host
Abstract
1. Introduction
2. Materials and Methods
2.1. Ethics Statement
2.2. Bacterial Strains and Growth Conditions
2.3. Sequence Analysis
2.4. Construction and Characterization of Crp Mutants
2.5. Resistance Against Host Clearance of E. piscicida
2.6. Virulence of E. piscicida Δcrp in Zebrafish and Catfish Fingerlings
2.7. Immune Protection of E. piscicida Δcrp Mutant in Zebrafish and Catfish Fingerlings
2.8. Statistical analysis
3. Results
3.1. Sequence Analysis
3.2. Construction and Characterization of Crp Mutants
3.3. Resistance Against Host Clearance of E. piscicida Δcrp
3.4. Virulence of E. piscicida Δcrp in Zebrafish and Catfish Fingerling
3.5. Immune Protection of E. piscicida Δcrp Mutant in Zebrafish and Catfish Fingerling
4. Discussion
5. Conclusions
Supplementary Materials
Author Contributions
Funding
Conflicts of Interest
References
- Abayneh, T.; Colquhoun, D.J.; Sorum, H. Edwardsiella piscicida sp. Nov., a novel species pathogenic to fish. J. Appl. Microbiol. 2013, 114, 644–654. [Google Scholar] [CrossRef] [PubMed]
- Mohanty, B.R.; Sahoo, P.K. Edwardsiellosis in fish: A brief review. J. Biosci. 2007, 32, 1331–1344. [Google Scholar] [CrossRef] [PubMed]
- Loch, T.P.; Hawke, J.P.; Reichley, S.R.; Faisal, M.; Del Piero, F.; Griffin, M.J. Outbreaks of edwardsiellosis caused by Edwardsiella piscicida and Edwardsiella tarda in farmed barramundi (Lates calcarifer). Aquaculture 2017, 481, 202–210. [Google Scholar] [CrossRef]
- Bujan, N.; Toranzo, A.E.; Magarinos, B. Edwardsiella piscicida: A significant bacterial pathogen of cultured fish. Dis. Aquat. Organ. 2018, 131, 59–71. [Google Scholar] [CrossRef] [PubMed]
- Ma, R.; Yang, G.; Xu, R.; Liu, X.; Zhang, Y.; Ma, Y.; Wang, Q. Pattern analysis of conditional essentiality (PACE)-based heuristic identification of an in vivo colonization determinant as a novel target for the construction of a live attenuated vaccine against Edwardsiella piscicida. Fish Shellfish Immunol. 2019, 90, 65–72. [Google Scholar] [CrossRef]
- Wang, Q.; Yang, M.; Xiao, J.; Wu, H.; Wang, X.; Lv, Y.; Xu, L.; Zheng, H.; Wang, S.; Zhao, G.; et al. Genome sequence of the versatile fish pathogen Edwardsiella tarda provides insights into its adaptation to broad host ranges and intracellular niches. PLoS ONE 2009, 4, e7646. [Google Scholar] [CrossRef]
- Munang’andu, H.M. Intracellular bacterial infections: A challenge for developing cellular mediated immunity vaccines for farmed fish. Microorganisms 2018, 6, E33. [Google Scholar] [CrossRef]
- Yamasaki, M.; Araki, K.; Maruyoshi, K.; Matsumoto, M.; Nakayasu, C.; Moritomo, T.; Nakanishi, T.; Yamamoto, A. Comparative analysis of adaptive immune response after vaccine trials using live attenuated and formalin-killed cells of Edwardsiella tarda in ginbuna crucian carp (Carassius auratus langsdorfii). Fish Shellfish Immunol. 2015, 45, 437–442. [Google Scholar] [CrossRef]
- Green, J.; Stapleton, M.R.; Smith, L.J.; Artymiuk, P.J.; Kahramanoglou, C.; Hunt, D.M.; Buxton, R.S. Cyclic-AMP and bacterial cyclic-AMP receptor proteins revisited: Adaptation for different ecological niches. Curr. Opin. Microbiol. 2014, 18, 1–7. [Google Scholar] [CrossRef]
- Colton, D.M.; Stabb, E.V. Rethinking the roles of CRP, cAMP, and sugar-mediated global regulation in the Vibrionaceae. Curr. Genet. 2016, 62, 39–45. [Google Scholar] [CrossRef]
- Shimada, T.; Fujita, N.; Yamamoto, K.; Ishihama, A. Novel roles of cAMP receptor protein (CRP) in regulation of transport and metabolism of carbon sources. PLoS ONE 2011, 6, e20081. [Google Scholar] [CrossRef] [PubMed]
- Curtiss, R.; Kelly, S.M. Salmonella typhimurium deletion mutants lacking adenylate cyclase and cyclic AMP receptor protein are avirulent and immunogenic. Infect. Immun. 1987, 55, 3035–3043. Available online: https://iai.asm.org/content/55/12/3035 (accessed on 1 December 1987). [CrossRef] [PubMed]
- Skorupski, K.; Taylor, R.K. Cyclic AMP and its receptor protein negatively regulate the coordinate expression of cholera toxin and toxin-coregulated pilus in Vibrio cholerae. Proc. Natl. Acad. Sci. USA 1997, 94, 265–270. [Google Scholar] [CrossRef] [PubMed]
- Petersen, S.; Young, G.M. Essential role for cyclic AMP and its receptor protein in Yersinia enterocolitica virulence. Infect. Immun. 2002, 70, 3665–3672. [Google Scholar] [CrossRef] [PubMed]
- Stapleton, M.; Haq, I.; Hunt, D.M.; Arnvig, K.B.; Artymiuk, P.J.; Buxton, R.S.; Green, J. Mycobacterium tuberculosis cAMP receptor protein (Rv3676) differs from the Escherichia coli paradigm in its cAMP binding and DNA binding properties and transcription activation properties. J. Biol. Chem. 2010, 285, 7016–7027. [Google Scholar] [CrossRef] [PubMed]
- Kennedy, M.J.; Yancey, R.J.; Sanchez, M.S.; Rzepkowski, R.A.; Kelly, S.M.; Curtiss, R. Attenuation and immunogenicity of Δcya Δcrp derivatives of Salmonella choleraesuis in pigs. Infect. Immun. 1999, 67, 4628–4636. Available online: http://www.ncbi.nlm.nih.gov/pubmed/10456909 (accessed on 12 June 2019). [CrossRef] [PubMed]
- Sheoran, A.S.; Timoney, J.F.; Tinge, S.A.; Sundaram, P.; Curtiss, R. Intranasal immunogenicity of a Δcya Δcrp-pabA mutant of Salmonella enterica serotype Typhimurium for the horse. Vaccine 2001, 19, 3787–3795. Available online: http://www.ncbi.nlm.nih.gov/pubmed/11395214 (accessed on 12 June 2019). [CrossRef]
- Rosu, V.; Chadfield, M.S.; Santona, A.; Christensen, J.P.; Thomsen, L.E.; Rubino, S.; Olsen, J.E. Effects of crp deletion in Salmonella enterica serotype Gallinarum. Acta Vet. Scand. 2007, 49, 14. [Google Scholar] [CrossRef]
- Valderrama, K.; Saravia, M.; Santander, J. Phenotype of Aeromonas salmonicida sp. salmonicida cyclic adenosine 3’,5’-monophosphate receptor protein (Crp) mutants and its virulence in rainbow trout (Oncorhynchus mykiss). J. Fish Dis. 2017, 40, 1849–1856. [Google Scholar] [CrossRef]
- Santander, J.; Mitra, A.; Curtiss, R. Phenotype, virulence and immunogenicity of Edwardsiella ictaluri cyclic adenosine 3’,5’-monophosphate receptor protein (Crp) mutants in catfish host. Fish Shellfish Immunol. 2011, 31, 1142–1153. [Google Scholar] [CrossRef]
- Zhang, Y. I-TASSER server for protein 3D structure prediction. BMC Bioinform. 2008, 9, 40. [Google Scholar] [CrossRef] [PubMed]
- Ji, Y.; Li, J.; Qin, Z.; Li, A.; Gu, Z.; Liu, X.; Lin, L.; Zhou, Y. Contribution of nuclease to the pathogenesis of Aeromonas hydrophila. Virulence 2015, 6, 515–522. [Google Scholar] [CrossRef] [PubMed]
- Kong, Q.; Liu, Q.; Roland, K.L.; Curtiss, R. Regulated delayed expression of rfaH in an attenuated Salmonella enterica serovar typhimurium vaccine enhances immunogenicity of outer membrane proteins and a heterologous antigen. Infect. Immun. 2009, 77, 5572–5582. [Google Scholar] [CrossRef] [PubMed]
- Chen, D.D.; Li, J.H.; Yao, Y.Y.; Zhang, Y.A. Aeromonas hydrophila suppresses complement pathways via degradation of complement C3 in bony fish by metalloprotease. Fish Shellfish Immunol. 2019, 94, 739–745. [Google Scholar] [CrossRef]
- Behreans, A.L.; Karber, L. Determination of LD50. In Screening Methods in Pharmacology; Academic Press: New York, NY, USA, 1953; p. 60. [Google Scholar]
- Kolb, A.; Busby, S.; Bue, H.; Garges, S.; Adhya, S. Transcriptional regulation by cAMP and its receptor protein. Annu. Rev. Biochem. 1993, 62, 749–795. [Google Scholar] [CrossRef]
- Weber, I.T.; Steitz, T.A. Structure of a complex of catabolite gene activator protein and cyclic AMP refined at 2.5 Å resolution. J. Mol. Biol. 1987, 198, 311–326. [Google Scholar] [CrossRef]
- Gorke, B.; Stulke, J. Carbon catabolite repression in bacteria: Many ways to make the most out of nutrients. Nat. Rev. Microbiol. 2008, 6, 613–624. [Google Scholar] [CrossRef]
- Botsford, J.L.; Harman, J.G. Cyclic AMP in prokaryotes. Asm. J. 1992, 56, 100–122. Available online: https://mmbr.asm.org/content/56/1/100 (accessed on 1 March 1992). [CrossRef]
- Busby, S.; Ebright, R.H. Transcription activation by catabolite activator protein (CAP). J. Mol. Biol. 1999, 293, 199–213. [Google Scholar] [CrossRef]
- Chandler, M.S. The gene encoding cAMP receptor protein is required for competence development in Haemophilus influenzae Rd. Proc. Natl. Acad. Sci. USA 1992, 89, 1626–1630. [Google Scholar] [CrossRef]
- Chagneau, C.; Heyde, M.; Alonso, S.; Portalier, R.; Laloi, P. External-pH-dependent expression of the maltose regulon and ompF gene in Escherichia coli is affected by the level of glycerol kinase. J. Bacteriol. 2001, 183, 5675–5683. [Google Scholar] [CrossRef] [PubMed][Green Version]
- Liang, W.; Pascual-Montano, A.; Silva, A.J.; Benitez, J.A. The cyclic AMP receptor protein modulates quorum sensing, motility and multiple genes that affect intestinal colonization in Vibrio cholera. Microbiology 2007, 153, 2964–2975. [Google Scholar] [CrossRef] [PubMed]
- Barrero-Tobon, A.M.; Hendrixson, D.R. Flagellar biosynthesis exerts temporal regulation of secretion of specific Campylobacter jejuni colonization and virulence determinants. Mol. Microbiol. 2014, 93, 957–974. [Google Scholar] [CrossRef] [PubMed]
- Josenhans, C.; Suerbaum, S. The role of motility as a virulence factor in bacteria. Int. J. Med. Microbiol. 2002, 291, 605–614. Available online: http://www.urbanfischer.de/journals/ijmm (accessed on 1 March 2002). [CrossRef]
- Choe, Y.; Park, J.; Yu, J.E.; Oh, J.I.; Kim, S.; Kang, H.Y. Edwardsiella piscicida lacking the cyclic AMP receptor protein (Crp) is avirulent and immunogenic in fish. Fish Shellfish Immunol. 2017, 68, 243–250. [Google Scholar] [CrossRef]
- Xiao, J.; Chen, T.; Liu, B.; Yang, W.; Wang, Q.; Qu, J.; Zhang, Y. Edwardsiella tarda mutant disrupted in type III secretion system and chorismic acid synthesis and cured of a plasmid as a live attenuated vaccine in turbot. Fish Shellfish Immunol. 2013, 35, 632–641. [Google Scholar] [CrossRef]

| Description | Source or reference | |
|---|---|---|
| Strains Edwardsiella piscicida EIB202 J118 Δcrp ΔPcrp Escherichia coli | CCTCC M208068, Colr, Cmr, pla+ pEIB202 curing derivative of EIB202, Colr, Cms, pla− crp deletion mutant ΔPcrpTT araC PBAD crp TT | [6] Lab stocking J118 J118 |
| χ7213 | thr-1 leuB6 fhuA21 lacY1 glnV44 recA1 ΔasdA4 Δ(zhf-2::Tn10) thi-1 | [16] |
| Plasmids pYA3700 pRE112 | TT araC PBAD cassette plasmid; Apr Suicide vector, sacB, mob−(RP4)R6K ori, Cmr | [23] |
| pRE112-crp pRE112-ΔPcrp | pRE112 derivative, designed for knockout of crp, Cmr pRE112 derivative, designed for replacement of crp promoter, Cmr | pRE112 pRE112 |
| Primer | Sequence (5’-3’) | Product Size (bp) | Tm | Target Gene | Source or Reference |
|---|---|---|---|---|---|
| P1 | CGCTCTAGACCACAGGACAAACCAAAACC | 593 | 58 | Upstream fragment for Δcrp | This study |
| P2 | TGCTGGAGGATCAGAACCTGATCTCGGCACACGGTAAAAC | construction | |||
| P3 | CAGGTTCTGATCCTCCAGCAGTTGGATCTGTTTGCGGTTT | 579 | 58 | Downstream fragment for Δcrp | This study |
| P4 | CCCGAGCTCAGAGACGCTGGATAGCCTGA | construction | |||
| P5 | CCCAGATCTTCTATACCCGCTTCATTCCA | 557 | 58 | Upstream fragment for ΔPcrp | This study |
| P6 | CGCAAGCTTCCCCGGGCCGTCCAATATCGAATACCA | construction | |||
| P7 | CGCCTCGAGGGATAATAGCGAATGGTTCTC | 595 | 58 | Downstream fragment for ΔPcrp | This study |
| P8 | CGCCTCGAGGGATAATAGCGAATGGTTCTC | construction |
| Dose of Challenge CFU | Number of Death/Total | Survival Rate (%) | ||
|---|---|---|---|---|
| J118 | Δcrp | J118 | Δcrp | |
| 1.0 × 107 | - | 10/10 | - | 0 |
| 1.0 × 106 | 10/10 | 6/10 | 0 | 40 |
| 1.0 × 105 | 8/10 | 3/10 | 20 | 70 |
| 1.0 × 104 | 6/10 | 1/10 | 40 | 90 |
| 1.0 × 103 | 2/10 | 0/10 | 80 | 100 |
| 1.0 × 102 | 0/10 | - | 100 | - |
| LD50* | 7.94 × 103 | 3.16 × 105 | ||
| Dose of Challenge CFU | Number of Death/Total | Survival Rate (%) | ||
|---|---|---|---|---|
| J118 | Δcrp | J118 | Δcrp | |
| 1.0 × 108 | - | 10/10 | - | 0 |
| 1.0 × 107 | 10/10 | 7/10 | 0 | 30 |
| 1.0 × 106 | 5/10 | 0/10 | 50 | 100 |
| 1.0 × 105 | 2/10 | - | 80 | - |
| 1.0 × 104 | 0/10 | - | 100 | - |
| LD50* | 6.31 × 105 | 6.31 × 106 | ||
© 2020 by the authors. Licensee MDPI, Basel, Switzerland. This article is an open access article distributed under the terms and conditions of the Creative Commons Attribution (CC BY) license (http://creativecommons.org/licenses/by/4.0/).
Share and Cite
Zhou, P.; Han, X.; Ye, X.; Zheng, F.; Yan, T.; Xie, Q.; Zhang, Y.-A.; Curtiss, R., III; Zhou, Y. Phenotype, Virulence and Immunogenicity of Edwardsiella piscicida Cyclic AMP Receptor Protein (Crp) Mutants in Catfish Host. Microorganisms 2020, 8, 517. https://doi.org/10.3390/microorganisms8040517
Zhou P, Han X, Ye X, Zheng F, Yan T, Xie Q, Zhang Y-A, Curtiss R III, Zhou Y. Phenotype, Virulence and Immunogenicity of Edwardsiella piscicida Cyclic AMP Receptor Protein (Crp) Mutants in Catfish Host. Microorganisms. 2020; 8(4):517. https://doi.org/10.3390/microorganisms8040517
Chicago/Turabian StyleZhou, Peng, Xueqing Han, Xiang Ye, Feifei Zheng, Ting Yan, Quan Xie, Yong-An Zhang, Roy Curtiss, III, and Yang Zhou. 2020. "Phenotype, Virulence and Immunogenicity of Edwardsiella piscicida Cyclic AMP Receptor Protein (Crp) Mutants in Catfish Host" Microorganisms 8, no. 4: 517. https://doi.org/10.3390/microorganisms8040517
APA StyleZhou, P., Han, X., Ye, X., Zheng, F., Yan, T., Xie, Q., Zhang, Y.-A., Curtiss, R., III, & Zhou, Y. (2020). Phenotype, Virulence and Immunogenicity of Edwardsiella piscicida Cyclic AMP Receptor Protein (Crp) Mutants in Catfish Host. Microorganisms, 8(4), 517. https://doi.org/10.3390/microorganisms8040517

